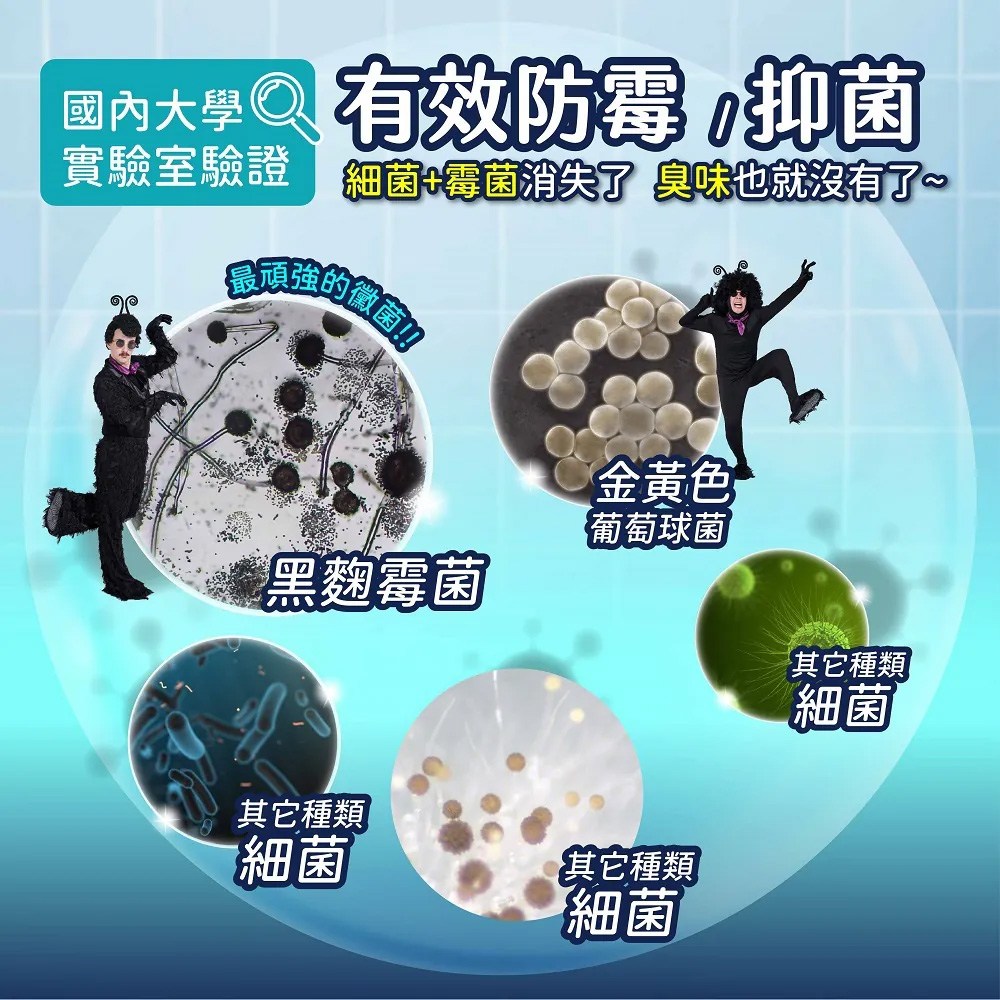

找相似
訂單成立賺10%
下單享LINE POINTS點數
訂單成立賺10%39 點設定到價通知
特力屋
相似商品熱銷排行榜商品描述
選擇您想逛的分類
相似商品熱銷排行榜商品描述
相似商品
找相似

$279(雙重省$47)
多益得 酵速(Bio-Enzy)地板抗菌清潔劑2000ml
特力屋
10%
找相似
降價
$4,680(降$520)
【海夫健康生活館】雙人床套優雅E級III精棉
鮮拾
2%
找相似
$219
南僑水晶葡萄柚籽洗衣精補充包 室內晾1200ml
Yahoo購物中心
0%
找相似
$100
醫強75%酒精液500ML含噴頭
日藥本舖官方網站
3%
找相似
$400
廚油寶500ml 日本技術 除油 油污清潔 廚房清潔劑 熊本潔淨劑
亞洲跨境設計購物平台 Pinkoi
1%
找相似
限時加碼
$169
花香爆炸鹽衣物生物酵素漂白水去漬增白彩漂粉彩色衣服留香洗衣粉
蝦皮購物
7.2%
找相似
降價
$189(降$10)
日本LEC - 【激落君】小蘇打泡沫去污噴劑400ml(日本製)
媽咪愛
0.5%
找相似
限時加碼
$199
多益得 環境消臭抗菌劑1000ml
特力屋
10%
找相似
$290
紅柿子 抗菌除臭噴劑 尤加利 ISQW-0900-5
Yahoo購物中心
0%
找相似
$499
202709台糖寡醣乳酸菌30入*1盒 含果寡醣 台糖益生菌
Yahoo購物中心
0%
找相似

$405(雙重省$46)
日本Asahipen-日本超效霉菌抑制噴霧 300ML
東森購物 ETMall
0.5%
找相似
$145
妙管家除臭抗菌超濃縮洗衣粉/2kg/盒
史泰博台灣
2%
找相似
歷史低價
$569(降$24)
【2入組】Zippets吉沛思軟膏 寵物萬用/寵物護掌 狗貓適用 15g (購買第二件贈送寵喵樂-貓草玩具x1包)
Yahoo購物中心
1%
找相似
$49
愛家環保分解袋-薰衣草(大)
家樂福線上購物
1%
找相似
$165
興農雷公殺蟲劑 0.5%水基乳劑 500ml
Yahoo購物中心
0%
找相似
限時加碼
$189
[家速配]鱷魚防霉抑菌煙霧劑-木隱之森
家樂福線上購物
1%
找相似
限時加碼
$198
紅柿子 抗菌除臭噴劑 尤加利 ISQW-0900-5
蝦皮商城
3%
找相似
$449
【日本Asahipen】日本超效霉菌抑制噴霧 300ML
Yahoo購物中心
0.3%
找相似
降價
$190(降$9)
【激落君】小蘇打泡沫去污噴劑(日本製)(去油汙/皮脂污垢)
亞洲跨境設計購物平台 Pinkoi
1%
找相似
降價
$668(降$332)
優得磁磚地板污漬清潔劑-500ml-3瓶
家樂福線上購物
10%
找相似
限時加碼
$49
[家速配]愛家環保分解袋-薰衣草(大)
家樂福線上購物
1%
找相似
$94
日本LEC-【激落君】廚房用除菌擦拭巾30枚入
Yahoo購物中心
0.3%
找相似
限時加碼
$145
【發票現貨】鱷魚 防霉抑菌蒸煙劑5g 除臭煙霧劑 孕婦寳寶適用 防霉4-8週 防霉 抗菌 水煙劑
蝦皮購物
4%
找相似
$199
荷生活 靜電除塵拖把-僅濕巾1包 不附拖把
Yahoo購物中心
0.3%
找相似
限時加碼
$1,680
金博氏 保衛菌 30包
蝦皮購物
10.8%
找相似
降價
$967(降$32)
do it 多益得 ALL Clean 酵素清潔劑 3785ml 廚房清潔、浴廁清潔、汽機車清潔皆適用 1桶
Coupang 酷澎
3.5%
找相似
降價
$444(降$55)
Good Boy Pet House 好寶貝寵物居家用品 寵物除臭噴劑原款 檸檬香茅 500ml 1瓶
Coupang 酷澎
3.5%
找相似
$59
KOKUBO 抗菌清潔海綿-速泡
寶雅線上買
0.5%
相關文章
IKEA缺貨好物再+1!Grejsimojs系列毛毛椅、長頸鹿燈…全系列價格一次看
在threads上討論度極高的IKEA全新限量系列Grejsimojs正式登場,從孩子的「玩樂力」出發,把家具、玩具與生活...
229人已觀看
三麗鷗角色你認得幾個呢?「三麗鷗展 FINAL ver.」200個角色齊聚東京六本木!
創立60週年的三麗鷗(Sanrio)即將在2026年春季帶來展覽盛事!「サンリオ展 ファイナル(FINAL) ver. ニ...
225人已觀看
能輕鬆說出心酸事的星座Top 3!牡羊容易放下,解悶就靠這療癒小物
有些人容易大驚小怪,一點點不順心就好像遭受一萬點傷害,好像世界要塌了。不過有些人即便有最心酸的經歷,也能輕鬆說出來,好像不...
52,504人已觀看
開工馬力全開!開工走春咖啡優惠一次整理,幫上班族把能量補好補滿
新的一年正式開工,馬年講求的就是馬力要夠、節奏要穩!小編這篇特別整理了幾個適合開工走春的咖啡優惠與點心選擇,從咖啡館、便利...
501人已觀看
濟州島冬季玩法推薦!雪白漢拏山、粉紅山茶花,少了人潮更好玩!
冬天的濟州島屬於旅遊淡季,但其實也非常好玩,少了夏季人潮,多了銀白雪景與清冽空氣,整座島嶼彷彿被時間放慢。從披上霧淞雪衣的...
158人已觀看
蛋黃控必吃!鹹蛋黃口味甜點零食8款推薦,蛋捲、流心酥讓人口水直流
鹹蛋黃總是給人一種嚐過就難以忘懷的美味,而最近有許多新上市的鹹蛋黃口味甜點零食,小編今天就要為大家推薦 8 款鹹蛋黃口味甜...
38,606人已觀看
2026台北燈節亮點一次看!12隻熊讚、柯博文小提燈限量發送,宮廟祈福一路亮到元宵
2026台北燈節將於2月25日至3月15日盛大登場,今年以「雙展區、雙IP」概念策展,串聯西門町周邊與花博公園兩大展區,結...
888人已觀看
【唐綺陽星座運勢週報2/23-3/1】處女感情避免內耗,獅子事業需向前看 | ELLE
本週火星衝刺在水瓶,網路紛爭衆多,政治局勢動盪、變化頻繁,當心刀火燙傷,注意用火安全,受水逆影響,3C產品容易故障。水逆雙...
936人已觀看
認準了就是一輩子!用深情書寫愛情傳奇 「最專情」5大星座是他們
在速食愛情盛行的時代,有些人仍選擇在浩瀚星空下守護最純粹的承諾。搜狐網分析指出,十二星座中有五大星座以「專情」與「深情」著...
492人已觀看
坐等加薪升職!3星座馬年工作運旺翻 天蠍財源滾滾、第一名「天降好運」
在職場上拚搏,除了仰賴自身過硬的專業能力,有時候「運氣」更是推動成功的關鍵一環。星座專家Amanda老師在節目《命運好好玩...
1,140人已觀看
熱銷排行榜
找相似
降價
$630(降$360)
艾葉菖蒲驅蚊包 60g*5(補充包) 熱烘香,藥檢,無外袋【1組5包/2組10包】
傳世生藥
0%
找相似
降價
$75(降$64)
OP抗蟑驅蠅植材袋-小15L
寶雅線上買
0.5%
找相似
$600
乾乾好 除濕劑補充包 Refill bag 4-pack (Series3 適用)(4包/盒)
三分之二生活設計
4%
找相似

$499(雙重省$405)
【驅塵氏】靜電除塵紙-無香/香氛/防螨(25片/包,12包/箱~箱購)
蝦皮商城
1%
找相似
$499
Combat威滅 抽屜除蟲片 10Px3包 (共30片) SPA/柑橘
Yahoo購物中心
0.3%
找相似
降價
$2,100(降$2,700)
智能UV殺菌包 3分鐘快速除菌 紫外線消毒包 收納包(香檳粉 馬卡灰)香檳粉
特力屋
0%
找相似
降價
$59(降$47)
輕時代 絕對乾燥 吊掛式除濕袋(檸檬清香)
家樂福線上購物
1%
找相似

$63(雙重省$22)
[家速配]克潮靈吊掛式除濕袋-無香
家樂福線上購物
1%
找相似
降價
$186(降$10)
farcent 花仙子 克潮靈 環保除濕桶 玫瑰香 350g 4個
Coupang 酷澎
3.5%
找相似
降價
$1,100(降$80)
Hoom禾馨生活 防水防貓抓沙發布 薄荷藍 380 x 180cm 1個
Coupang 酷澎
3.5%
找相似

$55(雙重省$16)
克潮靈~除濕桶補充包(3包) 檜木香/玫瑰香/去霉味/活性炭無香 款式可選
小三美日官網
5%
找相似

$139(雙重省$61)
[家速配]Combat威滅護效除蟲殺蟲劑500ml
家樂福線上購物
1%
找相似
$99
夜安寧廣效水蒸煙霧式殺蟲劑
家樂福線上購物
1%
找相似
$55
克潮靈-集水袋補充包400ml-去霉味-3入/組
Yahoo購物中心
0.3%
找相似
限時加碼
$233
Hakugen Earth 白元冰箱除臭劑 B082 綠盒 冷藏專用 25g 2個
Coupang 酷澎
3.5%
找相似
降價
$777(降$522)
GS MALL 台灣製造 超音波驅鼠機 驅鼠神器 超音波驅鼠 驅鼠 除蟲 驅鼠機
家樂福線上購物
10%
找相似
$2,880
【DigiMax】鼠來跑 雙效型超音波驅鼠蟲器 UP-1B1 三入組 [超音波驅鼠][磁震波驅蟲][特殊驅鼠光波]
Yahoo購物中心
0.3%
找相似

$159(雙重省$41)
[家速配]噴效蒸煙式殺蟲劑30克
家樂福線上購物
1%
找相似

$55(雙重省$14)
[家速配]克潮靈集水袋補充包-檜木香-180gx3
家樂福線上購物
1%
找相似

$788(雙重省$195)
《Digimax》強效型四合一超音波驅鼠器 UP-11H 驅鼠器 物理驅鼠 超音波驅鼠 人體無害 聲波驅鼠 驅趕 驅離
東森購物 ETMall
0.5%
找相似
$698
【日本Asahipen】榻榻米防蟲除菌清潔劑 250ML*二入 免水洗
Yahoo購物中心
0.3%
找相似
$1,180
iPhone Air SolidX 黑 - 哆啦A夢 Doraemon - 可怕的老鼠
RHINOSHIELD犀牛盾
2%
找相似
降價
$69(降$26)
花仙子 克潮靈 集水袋除濕盒 400ml 2入 玫瑰香
特力屋
10%
找相似
$449
克潮靈集水袋除濕盒-檜木配方(單盒) *12入
Yahoo購物中心
0.3%
找相似
$80
【厭世吶喊】 Li-good防水貼紙 春聯系列 - 萬用橫聯
亞洲跨境設計購物平台 Pinkoi
1%
找相似

$161(雙重省$38)
ST 雞仔牌 Drypet 備長炭吸濕包 除濕脫臭 適用於衣櫥/抽屜 12入 300g 1袋
Coupang 酷澎
3.5%
找相似
限時加碼
$79
【蝦皮直營】妙管家 霉菌殺手/水垢殺手補充瓶 750g
蝦皮直營_官方直營當日到
10%
找相似
降價
$170(降$10)
Magic Amah 妙管家 集水袋除濕盒 補充包 玫瑰花香 400ml 3入 4袋
Coupang 酷澎
3.5%
找相似
限時加碼
$54
【蝦皮直營】克潮靈 集水袋補充包(3入/組) 玫瑰香/檜木精油/去霉味
蝦皮直營_官方直營當日到
10%
找相似
限時加碼
$204
Y935 可掛式除濕盒 4組
Coupang 酷澎
3.5%
商品描述